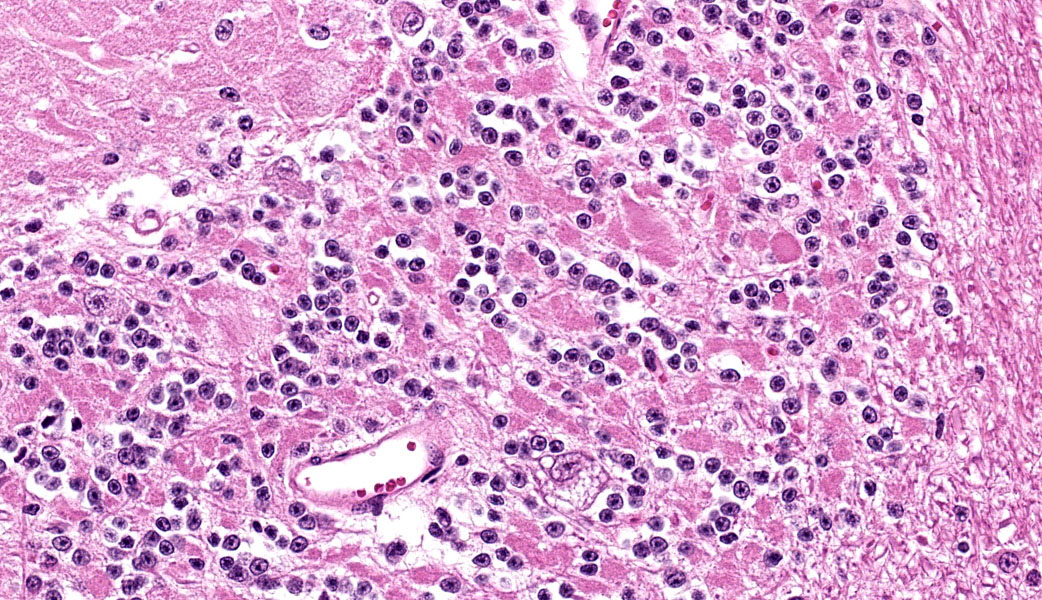

Conference 18, Case 4
Signalment:
4-month-old, female, Angus cow (Bos taurus)
History:
Calf presented with history of ongoing gener-alised ataxia, wide-based stance, incoordina-tion and intermittent head tremor. The calf was otherwise in good body condition. One other calf was similarly affected and there were 74 other unaffected calves in the herd.
Gross Pathology:
There was subjectively increased amount of CSF present upon removing the brain. A unilateral, focal, kidney cyst was also present.
Laboratory Results:
|
Test |
Result |
|
Blood lead |
Negative |
|
Chlamydia CFT |
Negative |
|
Pestivirus antigen capture ELISA |
Negative |
|
CBC & Biochemistry |
Mild Elevation GLDH – 15.09 (6.14-13.34 U/L) Moderate Elevation CK – 2401 (43-580 U/L) Mild Elevation AST – 133 (58-125 U/L) Mild elevation Leukocytes – 13.46 (4.8-13.0 U/L) Otherwise unremarkable |
|
CSF Analysis |
Colour: Opaque white Transparency: cloudy Flocculation: none Microprotein: 0.515 g/L Total nucleated cell count (TNCC): 0.725 x 109/L Red cell count: 0.005 x 1012/L Neutrophils: 22% Small mononuclear cells: 45% Large mononuclear cells: 33% Interpretation: Pleocytosis with elevated protein |
|
Neimann-Pick Type C genotyping PCR |
Non-carrier |
|
Alpha-mannosidosis genotyping PCR |
Affected |
Microscopic Description:
Cerebellum: Multifocally, numerous Purkinje cells at the junction between the molecular and granule cell layer, as well as occasional neurons within the granular cell layer and cerebellar deep nuclei are moderately swollen, have pale granular eosinophilic to clear, finely vacuolated or foamy cytoplasm that often dis-places the nuclei towards the periphery. Neurons are multifocally lost within the Purkinje (empty baskets) and granular layers. Through-out the white matter tracts, there are numerous variably sized (up to 60 μmin diameter) hypereosinophilic axonal swellings (spheroids) as well as less frequent dilation of periaxonal spaces containing fragmented myelin debris (ellipsoids) and foamy macrophages (digestion chambers). Multifocally, few axonal swellings are also present within the granule cell layer (torpedoes).
Contributor’s Morphologic Diagnoses:
Cerebellum: Neuronal vacuolation and loss, diffuse, severe with occasional neuronal intracellular granular eosinophilic material ac-cumulation, torpedoes, spheroids and digestion chambers (Wallerian degeneration).
Contributor’s Comment:
Alpha-mannosidosis is a type of inherited ly-sosomal storage disease predominantly seen in cattle.3 The condition is best characterized in Angus and Murray Grey cattle.3 It has also been reported in Galloway cattle as well as Persian, domestic longhair, and shorthair cats.2,7,12,15 The condition is rare in humans.
This storage disease was first described in An-gus calves in Australia in 1957 and later ex-tensively studied in New Zealand, becoming one of the earliest major investigations into lysosomal storage diseases in animals.18,24 Due to high economic impact, characterization of the disease and detection of both affected and carrier animals became a priority within the livestock industry. Clinically, affected ani-mals develop ill-thrift, ataxia, incoordination, head and intention tremors, often display a wide-based stance and can be abnormally ag-gressive.16,24 These signs can be seen as young as 4 weeks of age, with some animals able to survive up to 18 months of age.3,24
Individuals affected with alpha-mannosidosis are deficient in lysosomal alpha-mannosidase activity, leading to accumulation and storage of mannose within vacuoles of affected cells.3 Under light microscopy, these vacuoles are empty and expand the cytoplasm.16 The con-dition affects all cells within the body except hepatocytes, though is generally most noticeable microscopically within the nervous sys-tem.3 In this case, neuronal vacuolation was most prominent within the thalamus and in Purkinje cells of the cerebellum. Few renal tubular epithelial cells were also affected. In addition to neuronal vacuolation, dysfunction and death of neurons has led to other secondary changes such as Wallerian degeneration with prominent spheroid formation, as well as torpedoes.
Histologically, alpha-mannosidosis is typically indistinguishable from other forms of storage disease, however differentials can generally be narrowed down based on the breed affected. In this case, Neimann Pick Type C was also considered as a differential, given this lysosomal storage disease also affects Angus cattle.25 However, this condition has only been reported in one herd in Australia between 2002 and 2005.25 Other inherited storage diseases identified in cattle is summarized below (Table 1). While this case was confirmed to be inherited, acquired manno-sidosis is also possible in herbivorous species, particularly livestock. Ingestion of plants con-taining the indolizidine alkaloid swainsonine can lead to inhibition of alpha-mannosidase, resulting in similar effects to the inherited condition.5,6 Common swainsonine containing plants include Swainsonia spp. (Darling Pea and Swainson pea) mostly seen in Australia, as well as Oxytropis spp. and Astragalus spp. (locoweeds) found in areas of Africa, China and North America.9,14
Table 1: = Inherited storage diseases reported in cattle. 4,8,12,1313,20,21,22,23,24,27
|
Disorder |
Breeds affected |
|
Alpha-mannosidosis |
Angus, Galloway, Murray Grey |
|
Beta-mannosidosis |
Salers |
|
GM, gangliosidosis |
Holstein-Friesian |
|
Glycogen storage disease type II (Pompe's disease) |
Brahman, Droughtmaster, Shorthorn, Blanco Orejinegro |
|
Sphingomyelinosis (Neimann Pick type C) |
Angus |
|
Neuronal ceroid lipofuscinosis* |
Beefmaster, Devon, Holstein |
*This condition is generally histologically distinct from other storage diseases, as the accumulation of storage material within neurons is pigmented (yellow-brown).
Contributing Institution:
Elizabeth Macarthur Agricultural Institute (EMAi), NSW, DPIRD
https://www.dpi.nsw.gov.au/about-us/science-and-research_old/centres/emai
JPC Diagnoses:
Cerebellum: Neuronal vacuolation and loss, chronic, diffuse, severe, with axonal swelling.
JPC Comment:
This case provided a wonderful example of a lysosomal storage disease (LSD) in a bovine. Cattle are the poster children for many different LSDs amongst our domestic species, as mentioned by the contributor in their excellent comment. Other species with known genetic predispositions for certain LSDs include: Nubian goats and German shepherd dogs ( beta-mannosidosis), English Springer spaniel dogs (alpha-L-fucosidosis), and Persian cats (al-pha-mannosidosis). Particpants also learned a fun new term to describe the proliferation of microglia around Purkinje cells: “microglial shrubbery.”
Cattle affected with alpha-mannosidosis typically are slow to grow, develop progressive ataxia, exhibit behavioral changes, and do not live longer than 18 months.3 Most of their cells are affected by this condition except for hepatocytes. However, there is a case report in Gal-loway calves that reported consistent, severe hepatocyte vacuolation in calves diagnosed with alpha-mannosidosis, so it is possible that a spectrum of severity exists.11 In other species affected by alpha-mannosidosis, including cats, humans, and certain strains of mice, there is hepatocyte involvement. However, in bovine alpha-mannosidosis, the oligosaccharides that accumulate are similar to those seen in a partial deficiency of normal lysosomal alpha-mannosidase, meaning that they correspond to intermediates in the catabolic pathway.10 This suggests that there might be some residual activity of alpha-mannosidase in affected cattle. In comparison, the oligosaccharides that accumulate in cats, who are usually more severely affected by alpha-mannosidosis than cattle, are representative of intact moieties rather than intermediates, indicating that there is no residual activity.10 This may explain why the liver is generally less affected in cattle com-pared to other species.
Top differentials in this case discussed during conference included other LSDs, swainsonine toxicosis, and perennial ryegrass toxicosis (“ryegrass staggers”). Of these, perennial ryegrass is the only one not discussed by the contributor in their comment. “Ryegrass staggers” is caused by ingestion of ryegrass con-taining the endophytic fungus Epichloë festucae var. lolii (formerly known as Neotyphodium lolii). This fungus, while it has been demonstrated to work symbiotically with the ryegrass to increase its hardiness and sur-vivability, produces four indolic lolitrems that are tremorigenic neurotoxins. The most com-mon of these neurotoxins is lolitrem B. These toxins bind and inhibit calcium-activated potassium channels that are responsible for stoppage of action potentials in depolarizing neurons.3 Inhibition of these channels leads to prolonged cellular depolarization and sus-tained impulse transmission at the motor end-plate, causing sustained tremors and spasms in affected animals. Histologically, there are limited findings, but these can be similar to some of the lesions seen in an LSD. These include proximal axonal swelling (“torpedo for-mation”) in the granular and Purkinje cell layers of the cerebellum and vacuolar degeneration and loss of Purkinje cells.3 However, there will not be accumulation of material within cytoplasmic vacuoles, as seen with LSDs.
The JPC’s morphologic diagnosis for this case made use of the term “axonal swelling” to encompass the torpedoes, spheroids, and diges-tion chambers seen histologically, as all three of these are variations of axonal swelling at different portions of the neuron. Torpedoes are proximal swellings seen within the Purkinje and granular cell layers of the cerebellum; spheroids are swellings at the distal portions of the axons. Digestion chambers are the result of these swellings, where the axons are under-going Wallerian degeneration and are fragmenting. The JPC acknowledged that it is not wrong to list these things out individually. Participants simply chose to group them for the sake of brevity.
References:
-
- Bryan L, Schmutz S and Hodges SD et al. Bovine β-mannosidosis: pathologic and genetic findings in Salers calves. Veterinary Pathology. 1993;30(2):130-9.
- Burditt LJ, Chotai K and Hirani S et al. Biochemical studies on a case of feline mannosidosis. Biochemical Journal. 1980;189(3):467-73.
- Cantile C and Youssef S. Nervous System. In: Jubb, Kennedy and Palmer’s Pathology of Domestic Animals. Vol 2. 6th St. Louis, MO. Elsevier; 2016: 286-293.
- Caivio-Nasner S, López-Herrera A and González-Herrera LG et al. Frequency of genotypic markers for genetic disorders, colour, polledness, and major genes in Blanco Orejinegro cattle. Tropical Animal Health and Production. 2021;53:1-1.
- Cholich LA, Martinez A and Micheloud JF et al. Alpha-mannosidosis caused by toxic plants in ruminants of Argentina. Anais da Academia Brasileira de Ciências. 2021;93(suppl 3):e20191496.
- Cook D, Gardner DR and Welch KD et al. A survey of swainsonine content in Swainsona species. The Rangeland Journal. 2017;39(2):213-8.
- Cummings JF, Wood PA, De Lahunta A et al. The clinical and pathologic heterogeneity of feline alpha?Journal of veterinary internal medicine. 1988;2(4):163-70.
- Donnelly WJ and Sheahan BJ. GM1 gangliosidosis of Friesian calves: a review. Irish Veterinary Journal. 1981; 35(3):45-48, 51-55.
- Dorling PR, Huxtable CR and Colegate SM. Inhibition of lysosomal alpha-mannosidase by swainsonine, an indolizidine alkaloid isolated from Swainsona canescens. Biochemical Journal. 1980;191(2):649.
- Embury DH and Jerrett IV. Mannosidosis in Galloway calves. Veterinary pathology. 1985; 22(6): 548-551.
- Hafner S, Flynn S and Harmon BG et al. Neuronal ceroid-lipofuscinosis in a Holstein steer. Journal of veterinary diagnostic investigation. 2005;17(2):194-7.
- James LF, Kampen KR and Hartley WJ. Comparative pathology of Astragalus (locoweed) and Swainsona poisoning in sheep. Pathologia veterinaria. 1970;7(2):116-24.
- Jezyk PF, Haskins ME and Newman LR. Alpha-mannosidosis in a Persian cat. Journal of the American Veterinary Medical Association. 1986;189(11):1483-5.
- Jolly RD. The pathology of the central nervous system in pseudolipidosis of Angus calves. Journal of Pathology. 1971; 103:113-121.
- Jolly RD. Mannosidosis and its control in Angus and Murray Grey cattle. New Zealand Veterinary Journal. 1978;26(8):194-8.
- Jolly RD, Dittmer KE and Jones BR et al. Animal medical genetics: a historical perspective on more than 50 years of research into genetic disorders of animals at Massey University. New Zealand Veterinary Journal. 2021;69(5):255-66.
- Jolly RD, Martinus RD and Palmer DN. Sheep and other animals with ceroid?lipofuscinoses: Their relevance to Batten disease. American journal of medical genetics. 1992;42(4):609-14.
- Jolly RD, Van?De?Water NS and Richards RB et al. Generalized glycogenosis in beef shorthorn cattle—heterozygote detection. Australian Journal of Experimental Biology and Medical Science. 1977;55(2):141-50.
- Lyons RE, Johnston DJ and McGowan MR et al. E7 (1057ΔTA) mutation of the acidic α?glucosidase gene causes Pompe's disease in Droughtmaster cattle. Australian Veterinary Journal. 2017;95(5):138-42.
- O'Sullivan BM, Healy PJ and Fraser IR et al. Generalised glycogenosis in Brahman cattle. Australian Veterinary Journal. 1981;57(5):227-9.
- Read WK and Bridges CH. Neuronal Lipodystrophy. Occurrence in an Imbred Strain of Cattle. Pathologia veterinaria. 1969;6(3):235-43.
- Whittem JH, Walker D. “Neuronopathy" and" Pseudolipidosis" in Aberdeen-Angus calves. Journal of Pathology and Bacteriology. 1957; 74:281-288.
- Woolley SA, Tsimnadis ER and Lenghaus C et al. Molecular basis for a new bovine model of Niemann-Pick type C disease. Plos one. 2020;15(9):e0238697.